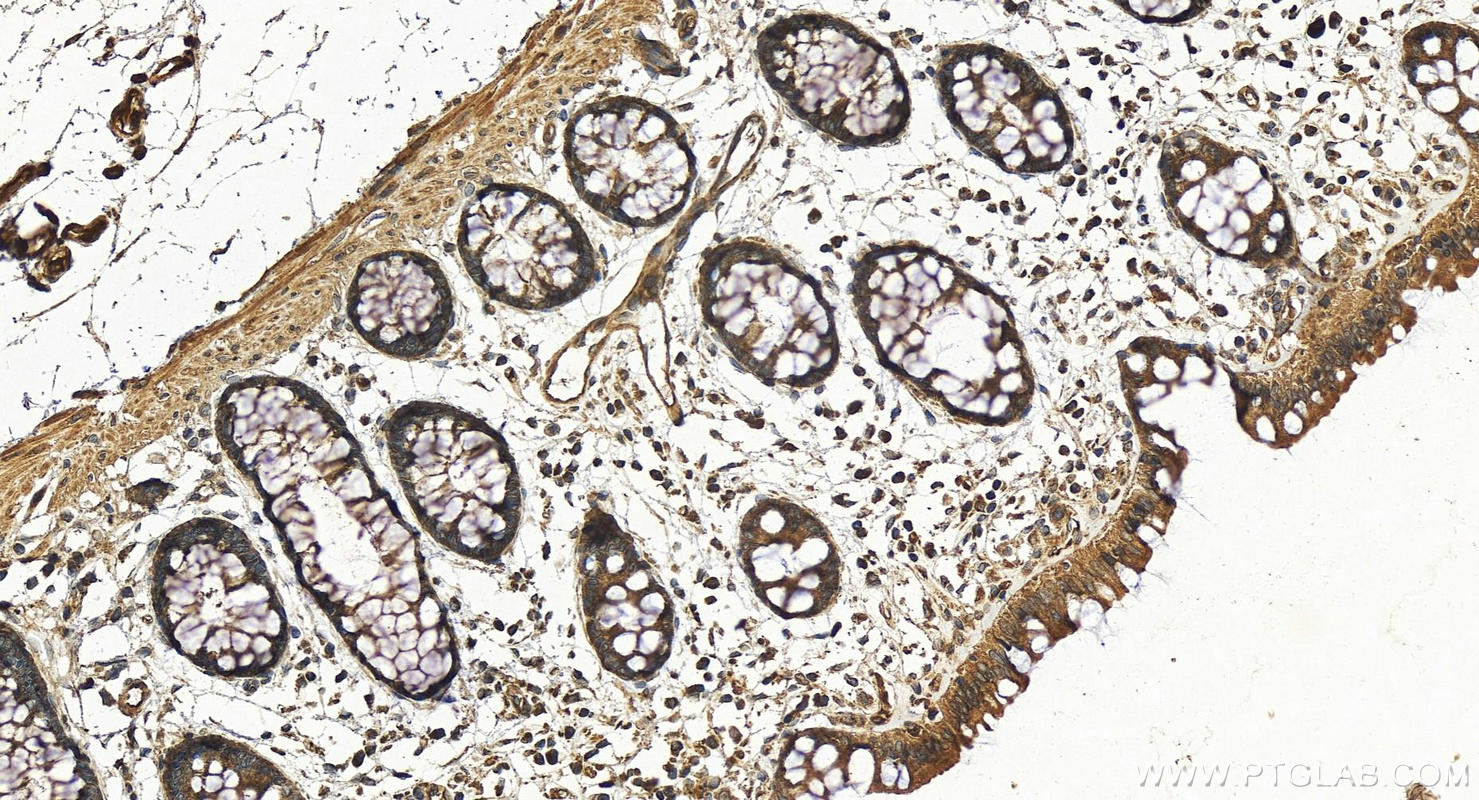
Immunohistochemistry (IHC) staining of human colon tissue using AVEN Polyclonal antibody (25846-1-AP)

Tested Applications
| Positive WB detected in | MCF-7 cells, K-562 cells |
| Positive IHC detected in | human colon tissue Note: suggested antigen retrieval with TE buffer pH 9.0; (*) Alternatively, antigen retrieval may be performed with citrate buffer pH 6.0 |
Recommended dilution
| Application | Dilution |
|---|---|
| Western Blot (WB) | WB : 1:500-1:2000 |
| Immunohistochemistry (IHC) | IHC : 1:50-1:500 |
| It is recommended that this reagent should be titrated in each testing system to obtain optimal results. | |
| Sample-dependent, Check data in validation data gallery. | |
Published Applications
| WB | See 2 publications below |
Product Information
25846-1-AP targets AVEN in WB, IHC, ELISA applications and shows reactivity with human samples.
| Tested Reactivity | human |
| Cited Reactivity | human |
| Host / Isotype | Rabbit / IgG |
| Class | Polyclonal |
| Type | Antibody |
| Immunogen |
CatNo: Ag23020 Product name: Recombinant human AVEN protein Source: e coli.-derived, PGEX-4T Tag: GST Domain: 1-362 aa of BC010488 Sequence: MQAERGARGGRGRRPGRGRPGGDRHSERPGAAAAVARGGGGGGGGDGGGRRGRGRGRGFRGARGGRGGGGAPRGSRREPGGWGAGASAPVEDDSDAETYGEENDEQGNYSKRKIVSNWDRYQDIEKEVNNESGESQRGTDFSVLLSSAGDSFSQFRFAEEKEWDSEASCPKQNSAFYVDSELLVRALQELPLCLRLNVAAELVQGTVPLEVPQVKPKRTDDGKGLGMQLKGPLGPGGRGPIFELKSVAAGCPVLLGKDNPSPGPSRDSQKPTSPLQSAGDHLEEELDLLLNLDAPIKEGDNILPDQTSQDLKSKEDGEVVQEEEVCAKPSVTEEKNMEPEQPSTSKNVTEEELEDWLDSMIS Predict reactive species |
| Full Name | apoptosis, caspase activation inhibitor |
| Calculated Molecular Weight | 39 kDa |
| Observed Molecular Weight | 50 kDa |
| GenBank Accession Number | BC010488 |
| Gene Symbol | AVEN |
| Gene ID (NCBI) | 57099 |
| RRID | AB_2880266 |
| Conjugate | Unconjugated |
| Form | Liquid |
| Purification Method | Antigen affinity purification |
| UNIPROT ID | Q9NQS1 |
| Storage Buffer | PBS with 0.02% sodium azide and 50% glycerol, pH 7.3. |
| Storage Conditions | Store at -20°C. Stable for one year after shipment. Aliquoting is unnecessary for -20oC storage. 20ul sizes contain 0.1% BSA. |
Background Information
AVEN (Apoptosis caspase activation inhibitor) is known to play a role in male and female germ cell development. AVEN protein has also been shown to inhibit the mitochondrial apoptosis pathway by binding to and inhibiting the self-association of proapoptotic APAF-1, as well as binding to and enhancing antiapoptotic BCL-xL activity. AVEN has also recently been shown to function as an activator of the cell cycle-regulating ATM kinase in the DNA damage response pathway. Molecular weight of this protein detected by WB is 50 kDa (PMID: 22751129).
Protocols
| Product Specific Protocols | |
|---|---|
| IHC protocol for AVEN antibody 25846-1-AP | Download protocol |
| WB protocol for AVEN antibody 25846-1-AP | Download protocol |
| Standard Protocols | |
|---|---|
| Click here to view our Standard Protocols |
Publications
| Species | Application | Title |
|---|---|---|
Open Med (Wars) Tanshinone IIA reverses oxaliplatin resistance in colorectal cancer through microRNA-30b-5p/AVEN axis. | ||
Front Oncol Integrative proteomics and m6A microarray analyses of the signatures induced by METTL3 reveals prognostically significant in gastric cancer by affecting cellular metabolism |